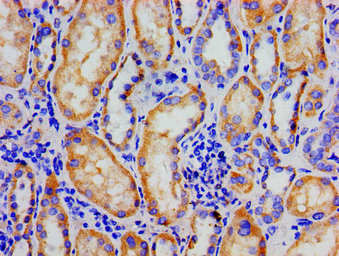

NR3C1 Antibody
-
中文名稱:NR3C1兔多克隆抗體
-
貨號:CSB-PA016059LA01HU
-
規格:¥440
-
圖片:
-
Western Blot
Positive WB detected in: HepG2 whole cell lysate
All lanes: NR3C1 antibody at 3µg/ml
Secondary
Goat polyclonal to rabbit IgG at 1/50000 dilution
Predicted band size: 86, 82, 65, 61, 83, 79, 77, 76, 52, 51, 50 kDa
Observed band size: 86 kDa -
Immunohistochemistry of paraffin-embedded human kidney tissue using CSB-PA016059LA01HU at dilution of 1:100
-
Immunofluorescent analysis of HepG2 cells using CSB-PA016059LA01HU at dilution of 1:100 and Alexa Fluor 488-congugated AffiniPure Goat Anti-Rabbit IgG(H+L)
-
Immunoprecipitating NR3C1 in Hela whole cell lysate
Lane 1: Rabbit control IgG instead of CSB-PA016059LA01HU in Hela whole cell lysate. For western blotting, a HRP-conjugated Protein G antibody was used as the secondary antibody (1/5000)
Lane 2: CSB-PA016059LA01HU (8µg) + Hela whole cell lysate (500µg)
Lane 3: Hela whole cell lysate (20µg)
-
-
其他:
產品詳情
-
產品名稱:Rabbit anti-Homo sapiens (Human) NR3C1 Polyclonal antibody
-
Uniprot No.:
-
基因名:
-
別名:GCCR antibody; GCR antibody; GCR_HUMAN antibody; GCRST antibody; glucocorticoid nuclear receptor variant 1 antibody; Glucocorticoid receptor antibody; GR antibody; GRL antibody; Grl1 antibody; nr3c1 antibody; Nuclear receptor subfamily 3 group C member 1 antibody; nuclear receptor subfamily 3, group C, member 1 (glucocorticoid receptor) antibody
-
宿主:Rabbit
-
反應種屬:Human
-
免疫原:Recombinant Human Glucocorticoid receptor protein (1-190AA)
-
免疫原種屬:Homo sapiens (Human)
-
標記方式:Non-conjugated
本頁面中的產品,NR3C1 Antibody (CSB-PA016059LA01HU),的標記方式是Non-conjugated。對于NR3C1 Antibody,我們還提供其他標記。見下表:
-
克隆類型:Polyclonal
-
抗體亞型:IgG
-
純化方式:>95%, Protein G purified
-
濃度:It differs from different batches. Please contact us to confirm it.
-
保存緩沖液:Preservative: 0.03% Proclin 300
Constituents: 50% Glycerol, 0.01M PBS, pH 7.4 -
產品提供形式:Liquid
-
應用范圍:ELISA, WB, IHC, IF, IP
-
推薦稀釋比:
Application Recommended Dilution WB 1:500-1:5000 IHC 1:20-1:200 IF 1:50-1:200 IP 1:200-1:2000 -
Protocols:
-
儲存條件:Upon receipt, store at -20°C or -80°C. Avoid repeated freeze.
-
貨期:Basically, we can dispatch the products out in 1-3 working days after receiving your orders. Delivery time maybe differs from different purchasing way or location, please kindly consult your local distributors for specific delivery time.
-
用途:For Research Use Only. Not for use in diagnostic or therapeutic procedures.
相關產品
靶點詳情
-
功能:Receptor for glucocorticoids (GC). Has a dual mode of action: as a transcription factor that binds to glucocorticoid response elements (GRE), both for nuclear and mitochondrial DNA, and as a modulator of other transcription factors. Affects inflammatory responses, cellular proliferation and differentiation in target tissues. Involved in chromatin remodeling. Plays a role in rapid mRNA degradation by binding to the 5' UTR of target mRNAs and interacting with PNRC2 in a ligand-dependent manner which recruits the RNA helicase UPF1 and the mRNA-decapping enzyme DCP1A, leading to RNA decay. Could act as a coactivator for STAT5-dependent transcription upon growth hormone (GH) stimulation and could reveal an essential role of hepatic GR in the control of body growth.; Has transcriptional activation and repression activity. Mediates glucocorticoid-induced apoptosis. Promotes accurate chromosome segregation during mitosis. May act as a tumor suppressor. May play a negative role in adipogenesis through the regulation of lipolytic and antilipogenic gene expression.; Acts as a dominant negative inhibitor of isoform Alpha. Has intrinsic transcriptional activity independent of isoform Alpha when both isoforms are coexpressed. Loses this transcription modulator function on its own. Has no hormone-binding activity. May play a role in controlling glucose metabolism by maintaining insulin sensitivity. Reduces hepatic gluconeogenesis through down-regulation of PEPCK in an isoform Alpha-dependent manner. Directly regulates STAT1 expression in isoform Alpha-independent manner.; Has lower transcriptional activation activity than isoform Alpha. Exerts a dominant negative effect on isoform Alpha trans-repression mechanism.; Increases activity of isoform Alpha.; More effective than isoform Alpha in transcriptional activation, but not repression activity.; Has transcriptional activation activity.; Has transcriptional activation activity.; Has transcriptional activation activity.; Has highest transcriptional activation activity of all isoforms created by alternative initiation. Has transcriptional repression activity. Mediates glucocorticoid-induced apoptosis.; Has transcriptional activation activity.; Has transcriptional activation activity.; Has lowest transcriptional activation activity of all isoforms created by alternative initiation. Has transcriptional repression activity.
-
基因功能參考文獻:
- relaxin-GR signaling has role in hepatocellular protection against ischemia-reperfusion stress in liver transplantation PMID: 29350771
- Bcl1 G/G polymorphism of glucocorticoid receptor gene is associated with bronchial asthma complicated by obesity. PMID: 30480407
- topical mevastatin accelerates wound closure by promoting epithelialization via multiple mechanisms: modulation of GR ligands and induction of the long noncoding RNA Gas5, leading to c-Myc inhibition. PMID: 29158265
- alpha-Viniferin (KCV) inhibits the activation of glucocorticoid receptor (GR) signaling pathway in non-androgen-dependent Prostate cancer (PCa) cells. KCV induces cancer cell apoptosis through AMP-Activated Protein Kinases-mediated activation of autophagy, and inhibits GR expression in castration-resistant prostate cancer(CRPC). PMID: 29904891
- The genotypes for the NR3C1 polymorphisms in patients and controls were distributed as follows: rs6191 TT 37 : 56, GT 178 : 36, GG 332 : 609; rs6196 AA 483 : 905, AG 66 : 118, GG 2 : 4; rs10482614 GG 493 : 916, AG 61 : 108, AA 1 : 4; and rs72557310 AG 27 : 65, GG 3 : 0, AA 525 : 964. There were no significant differences in genotype frequency or in allele distributions between cases and controls. PMID: 29381656
- Glucocorticoid receptor positively regulates transcription of FNDC5 in the liver. PMID: 28240298
- Polymorphisms in NR3C1 gene is associated with sensitivity to glucocorticoids and it may contribute to the glucose abnormality for Acute Lymphoblastic Leukemia. PMID: 29802709
- NR3C1 methylation moderates the effect of maternal support during stress on anxious attachment development 18 months later. More stressed children who experienced less maternal support reported increased anxious attachment when their NR3C1 gene was highly methylated. This effect could not be explained by children's level of psychopathology. PMID: 29058930
- Meta-analysis showed that homozygous mutation of NR3C1 rs41423247 was associated with Depression. PMID: 30278546
- This review focuses on the earlier findings on the pathophysiology of GR signaling and presents criteria facilitating identification of novel NR3C1 mutations in selected patients. [review] PMID: 29685454
- study indicates that GR genetic polymorphisms may play a major role in the pathogenesis and development of systemic lupus erythematosus PMID: 28984075
- The BclI NR3C1 polymorphisms were significantly associated with asthma in adults. (Meta-analysis) PMID: 29729712
- Here we show genome-wide that blocked GBR generally require CHD9 and BRM for GR occupancy in contrast to GBR that are not blocked by Hic-5. Hic-5 blocked GBR are enriched near Hic-5 blocked GR target genes but not near GR target genes that are not blocked by Hic-5. PMID: 29738565
- There was no significant association between different genotypes and alleles of Glucocorticoid Receptor of rs6195, rs6189/rs6190 variants, and response to fluoxetine (p=0.213 and 0.99, respectively). PMID: 28641498
- NR3C1 gene polymorphisms are significantly associated with the response to glucocorticoids. PMID: 29207898
- There is no clear evidence that the analysed NR3C1 allelic variants confer a risk for developing systemic autoimmune diseases although the minor G allele of rs41423247 may be protective among Caucasians (review and meta-analysis). PMID: 29526633
- Analyses demonstrated a trend in the association between maternal trait anxiety and depression symptoms with placental gene expression of NR3C1. We found a significant interaction with maternal ethnicity. In Caucasians only, prenatal trait anxiety and depressive symptoms were associated with an increase in placental NR3C1 expression, and prenatal life events were associated with a down regulation of HSD11B2 PMID: 29100173
- We genotyped 10 single nucleotide polymorphisms (SNPs) on the NR3C1 gene (rs10482682, rs33389, rs10482633, rs10515522, rs2963156, rs4128428, rs9324918, rs41423247, rs6189, rs10052957).Haplotype analyses revealed significant effects of NR3C1 (p = 0.011) on cortisol stress response. Neither NR3C1 haplotype nor NR3C2 haplotype was associated with reasoning abilities. PMID: 29100174
- In this study, we described the cellular localization of the glucocorticoid receptor in the human adult and fetal testis and provided evidence of an association between semen quality and a genetic polymorphism BclI (rs41423247) in the NR3C1 gene. PMID: 28992366
- Results indicate that maltreated children evidence higher baseline levels of NR3C1 methylation, significant decreases in methylation over time, and then at follow-up, lower levels of methylation, relative to nonmaltreated preschoolers. PMID: 29162170
- children with early onset maltreatment evidence significant hypermethylation compared to nonmaltreated children. Also, hypermethylation of NR3C1 is linked with a number of negative child outcomes including greater emotional lability-negativity, higher levels of ego undercontrol, more externalizing behavior, and greater depressive symptoms. PMID: 29162187
- Study evaluated whether associations between early adversity and brain responses to dynamic facial expressions in early adulthood varied as a function of regional differences in the expression of NR3C1. Strongest associations between adversities and BOLD response to fearful faces were in brain regions with higher NR3C1 mRNA expression levels. Highest expression of NR3C1 is found in occipital and lowest in temporal regions PMID: 28612935
- Study define a distinct GRgamma driven signaling network including identification of GRgamma specific subcellular trafficking, target gene selection, and engagement of interacting proteins. Both transcriptome, and protein interactome data suggested a role in for GRgamma in directing mitochondrial function, and indeed GRgamma expression increased mitochondrial mass, basal respiration, and ATP generation. PMID: 27226058
- Studied single nucleotide polymorphisms in human glucocorticoid receptor (NR3C1) gene with regard to susceptibility in high-altitude pulmonary edema (HAPE) in Han Chinese population. PMID: 29587872
- In patients with adrenal incidentalomas, a 5% prevalence of heterozygous NR3C1 mutations was discovered. PMID: 29444898
- This study demonstrated that NR3C1 expression levels are related to major depressive disorder and conjunctly mediate the effect of childhood maltreatment history on the risk of developing major depressive disorder. PMID: 28384542
- This study demonstrated that increased methylation of glucocorticoid receptor gene promoter 1F in peripheral blood of patients with generalized anxiety disorder. PMID: 28292649
- This study suggests that SNPs in the NR3C1 gene may influence BDNF levels in crack cocaine addiction. PMID: 28237884
- We identified a molecular signature of secreted proteins associated with AA ultraresponsiveness and sustained AR/GR signaling upon AA resistance in intermediate or minimal responders. These data will inform development of noninvasive biomarkers predicting AA response and suggest that further inhibition along the AR/GR signaling axis may be effective only in AA-resistant patients who are intermediate or minimal responders PMID: 27993966
- A Tri-Nucleotide Pattern in a 3' UTR Segment Affects The Activity of a Human Glucocorticoid Receptor Isoform PMID: 27660999
- Association Between N363S and BclI Polymorphisms of the Glucocorticoid Receptor Gene (NR3C1) and Glucocorticoid Side Effects During Childhood Acute Lymphoblastic Leukemia Treatment. PMID: 28179212
- genetic association studies in population in Brazil: Data suggest that an SNP in NR3C1 (A3669G) is associated with appetite regulation and food preferences; here, adolescents carrying A3669G variant exhibited decreased comfort food intake. PMID: 28400302
- Results provide evidence for an association between the NR3C1-rs41423247 SNP and depression: C minor allele of rs41423247 increased depressive symptoms during early abstinence of women with crack cocaine addiction, but it did not have effects over detoxification treatment. A slight effect of CC genotype was shown at late abstinence phase. C allele of this SNP was associated to an increased number of rehospitalizations. PMID: 27397864
- There was no significant interaction between NR3C1 and stressful life events with respect to alcohol use/misuse. PMID: 26751645
- Dehydroepiandrosterone (DHEA) and cortisol modulate SRSF9 and SRSF3 in a different way and data suggest that the anti-glucocorticoid effect of DHEA, among other mechanisms, is also exerted by modulating the expression of proteins involved in the splicing of the GR pre-mRNA. PMID: 28373129
- Association between suicide and altered NR3C1 gene expression in the prefrontal cortex. PMID: 27030168
- Results identified three novel heterozygous missense NR3C1 mutations causing glucocorticoid resistance in patients with adrenal incidentalomas without Cushing's syndrome. p.R477S and p.Y478C are located in the DNA binding domain (DBD) of the glucocorticoid receptor (GR) while p.L67P is located in the ligand binding domain of GR. PMID: 27120390
- Data show that the 3' UTR of glucocorticoid receptor beta (GRbeta) is regulated by miR144. PMID: 27036026
- Except for a slightly higher risk of bronchopulmonary dysplasia (BPD) in carriers of the GRBclI variant, the glucocorticoid receptor gene polymorphisms BclI, N363S, and R23K did not affect neonatal outcome parameters in this large multicenter cohort of Very-Low-Birth-Weight preterm infants. PMID: 27509264
- Possible influence of BclI C/G polymorphism (rs41423247) on hippocampal shape and integrity of the parahippocampal subdivision of the cingulum in depression. PMID: 27428087
- A woman with glucocorticoid resistance and her mother had a novel p.Arg477Cys (c.1429C>T) mutation in exon 4 of NR3C1, in the 2dzinc finger of the DNA-binding domain. Its 'in silico' functional effect was assessed using pathogenicity prediction software, being characterized as pathogenic. An unrelated patient had a novel p.His588Leufs*5 (c.1762_1763insTTAC) mutation, in exon 6, in the ligand binding domain. PMID: 27211791
- NR3C1 as an important gene of the hypothalamic-pituitary-adrenal axis seems to be particularly relevant for the pathophysiology of ADHD combined with comorbid CD. PMID: 27741480
- a significant protein-protein interaction between GR and CHOP, (GR-CHOP heterocomplex formation) under endoplasmic reticulum stress conditions, is reported. PMID: 27496643
- Childhood Maltreatment and MDD are both associated wit haltered DNA methylation levels in the NR3C1 promoter region, however the location and direction of effects differ between the two exposure.s PMID: 27475889
- This study presents evidence of reduced methylation of NR3C1 in association with childhood maltreatment and depressive, anxiety and substance-use disorders in adults. PMID: 27378548
- genetic association studies in a racially diverse population in North Carolina: Data suggest that an SNP in NR3C1 (rs6191, G3134T, "glucocorticoid receptor beta") is associated with altered gene expression profile in primary macrophages; minor allele frequency is 74% with a higher prevalence in Caucasian non-Hispanic participants. PMID: 28759007
- Decreased DNA methylation of CpG1 of NR3C1 in high-risk infants may allow for increased binding of transcription factors involved in the stress response, repair and regulation of NR3C1. This may ensure healthy growth in high-risk preterm infants over increasing cortisol levels. PMID: 27653086
- G-allele was associated with childhood overweight, depressive disorder comorbidity, and diagnostic instability. G-allele carriers reporting childhood overweight showed greater frequency of subjective binge eating and emotional eating. PMID: 27400218
- haplotype TAAT of GR might be a protective factor against aggressive behavior, while gene-gene interactions between GR rs1800445 and MR (NR3C2) rs2070951 might be a risk factor for aggressive behavior in the Central South Chinese Han population PMID: 28686058
- Glucocorticoid receptor (GR) is recruited to activator protein-1 (AP-1) target genes in a DNA-binding-dependent manner. PMID: 28591827
顯示更多
收起更多
-
相關疾病:Glucocorticoid resistance, generalized (GCCR)
-
亞細胞定位:[Isoform Alpha]: Cytoplasm. Nucleus. Mitochondrion. Cytoplasm, cytoskeleton, spindle. Cytoplasm, cytoskeleton, microtubule organizing center, centrosome.; [Isoform Beta]: Nucleus. Cytoplasm.; [Isoform Alpha-B]: Nucleus. Cytoplasm.
-
蛋白家族:Nuclear hormone receptor family, NR3 subfamily
-
組織特異性:Widely expressed including bone, stomach, lung, liver, colon, breast, ovary, pancreas and kidney. In the heart, detected in left and right atria, left and right ventricles, aorta, apex, intraventricular septum, and atrioventricular node as well as whole a
-
數據庫鏈接:
Most popular with customers
-
-
YWHAB Recombinant Monoclonal Antibody
Applications: ELISA, WB, IHC, IF, FC
Species Reactivity: Human, Mouse, Rat
-
Phospho-YAP1 (S127) Recombinant Monoclonal Antibody
Applications: ELISA, WB, IHC
Species Reactivity: Human
-
-
-
-
-